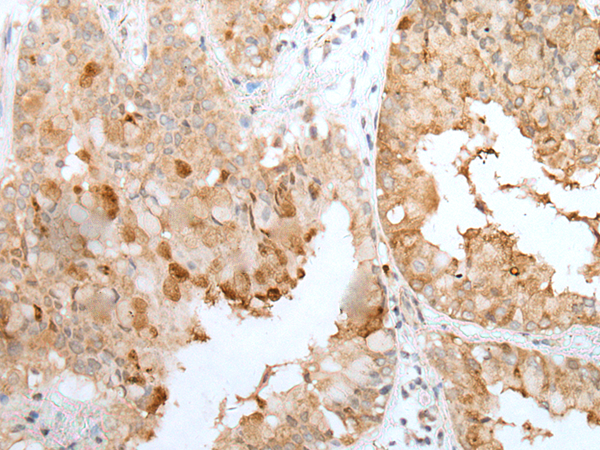

|
Background: |
The protein encoded by this gene is a secreted chaperone that can under some stress conditions also be found in the cell cytosol. It has been suggested to be involved in several basic biological events such as cell death, tumor progression, and neurodegenerative disorders. Alternate splicing results in both coding and non-coding variants. |
|
Applications: |
ELISA, IHC |
|
Name of antibody: |
CLU/APO J |
|
Immunogen: |
Fusion protein of human CLU/APO J |
|
Full name: |
clusterin |
|
Synonyms: |
CLI; AAG4; APOJ; CLU1; CLU2; KUB1; SGP2; APO-J; SGP-2; SP-40; TRPM2; TRPM-2; NA1/NA2 |
|
SwissProt: |
P10909 |
|
ELISA Recommended dilution: |
5000-10000 |
|
IHC positive control: |
Human brain and human liver cancer |
|
IHC Recommend dilution: |
50-350 |
購物車
幫助
021-54845833/15800441009
